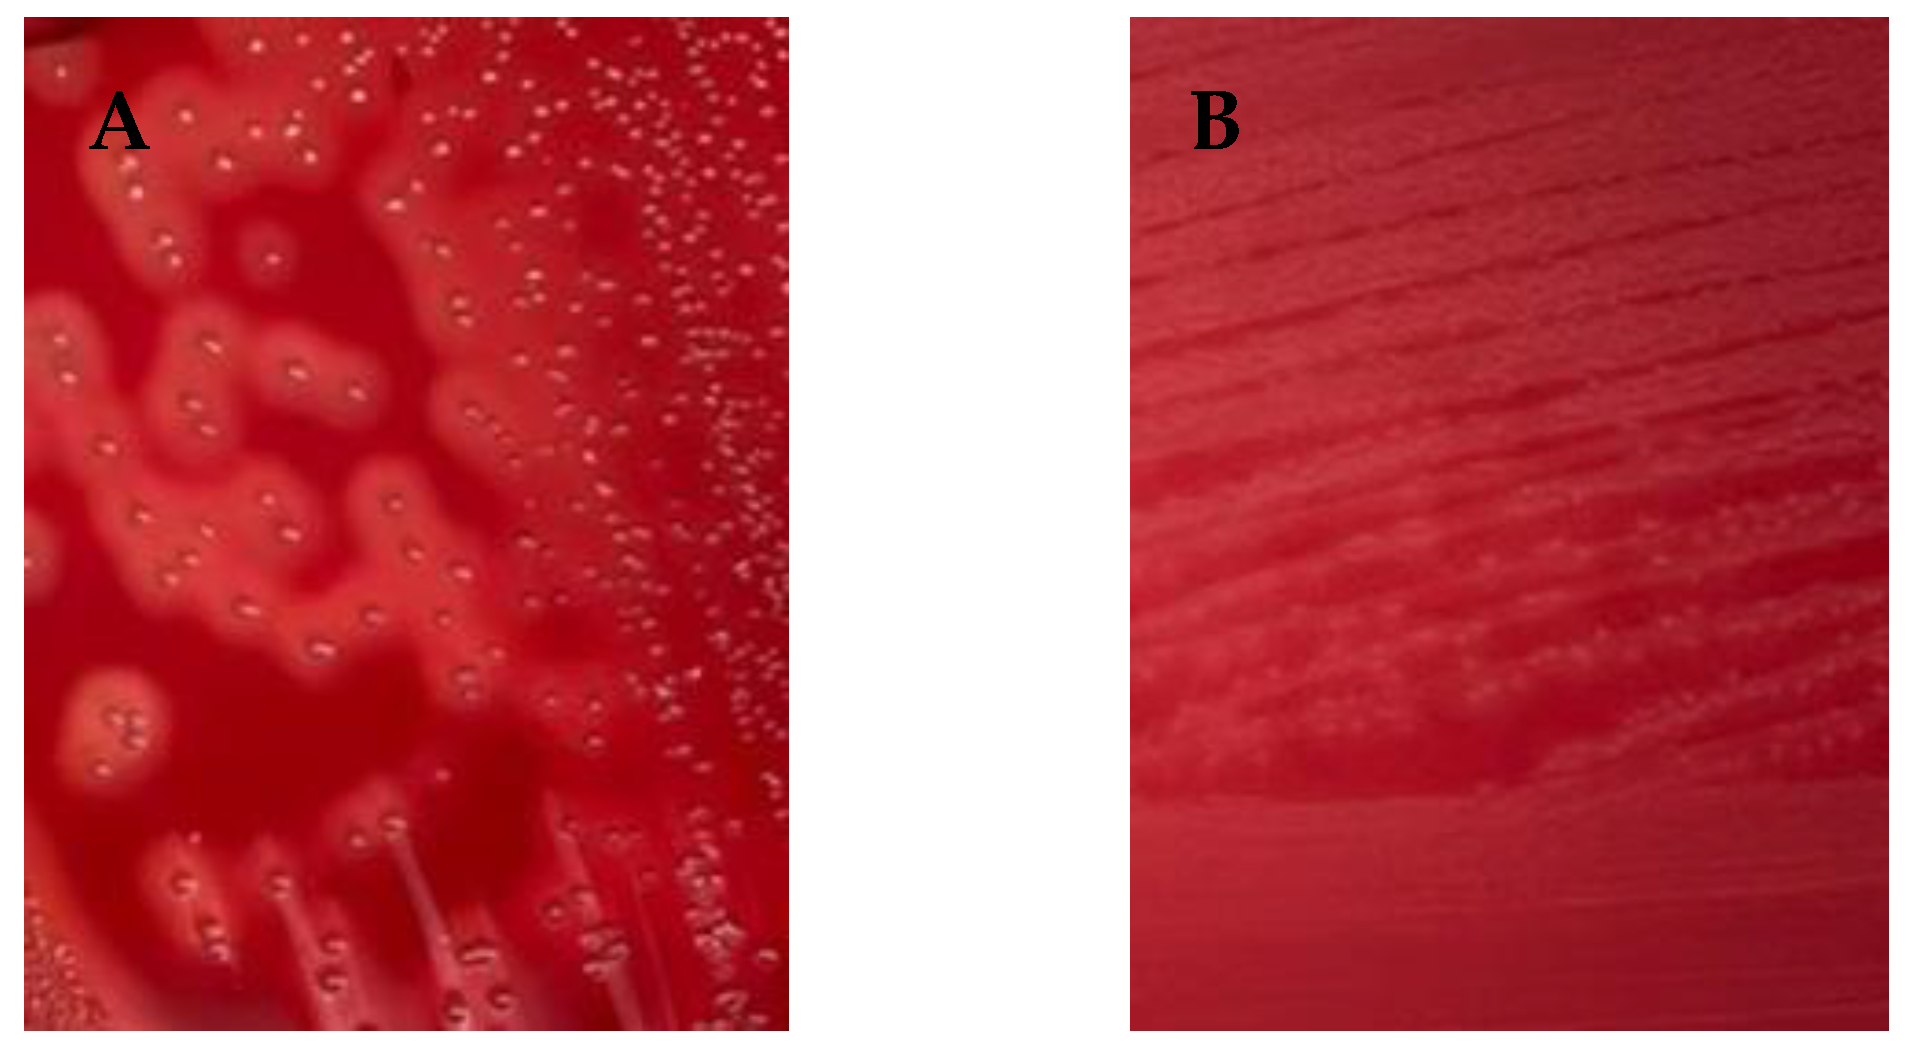
Animals 14 00447 g001

Simple Summary
We characterized ten virulent genes from Streptococcus agalactiae strains isolated from bovine mastitis (n = 100). The strains have at least three virulence genes essential for establishing intramammary infection. The presence of such virulence factors did not show a significant association with clinical and subclinical mastitis. The antimicrobial susceptibility of these strains suggests that beta-lactam antibiotics are recommended for the treatment of S. agalactiae mastitis in our region. Interestingly, we identified multidrug-resistant S. agalactiae strains (n = 7), with two strains being resistant to vancomycin. This evidence highlights significant concerns regarding the judicious use of antimicrobials in mastitis treatment protocols.
Abstract
Streptococcus agalactiae is a contagious pathogen that causes bovine mastitis. The ability of S. agalactiae to cause widespread mastitis relies on bacterial virulence factors. In this study, we detected 10 virulence determinants associated with mastitis pathogenicity using conventional PCR. The antimicrobial susceptibility of 100 S. agalactiae isolates from 13 Thai dairy herds was assessed using the Kirby–Bauer disk diffusion susceptibility test. All strains had at least three virulence factors responsible for invasion, adhesion, and infection (fbsB, bibA, and cfb, respectively). The predominant virulent profile of S. agalactiae strains revealed the presence of fbsA, fbsB, bibA, cfb, and cyl (n = 96). Most strains were sensitive to penicillin, ampicillin, amoxicillin-clavulanic acid, cefotaxime, ceftiofur, erythromycin, sulfamethoxazole-trimethoprim, and vancomycin. However, all strains were resistant to aminoglycosides, including kanamycin and gentamicin attributed to the unnecessary antimicrobial use. Furthermore, we identified seven multidrug resistant (MDR) S. agalactiae strains among four dairy herds, of which, two were vancomycin resistant. Our study provides profiles for virulence factors and antimicrobial susceptibility, which are beneficial for the clinical monitoring, prevention, and control of bovine mastitis in dairy cattle in Thailand. Moreover, we emphasize the need for awareness regarding the judicious use of antimicrobials on dairy farms.
1. Introduction
Streptococcus agalactiae is a contagious pathogen associated with bovine mastitis. This is a leading cause of intramammary infection causing economic loss in dairy farms globally. It is an etiological agent of clinical and subclinical mastitis that reduces milk yield and affects milk quality [1,2]. The incidence of bovine mastitis caused by S. agalactiae has decreased due to intensive control programs in developed countries [3]. However, China and Denmark have reported it as a reemerging pathogen [2,4]. In Thailand, animal-level prevalence of S. agalactiae causing mastitis ranges from 20 to 46.30% [5]. However, in the Khon Kaen province, bulk tank milk analysis indicated that 21.8% of the studied herds were positive for this pathogen [6]. Furthermore, a study indicated that S. agalactiae could persist on dairy farms for 2–12 months [7]. The presence of S. agalactiae in the herd negatively influenced the total bacterial counts and bulk milk somatic cell counts, demonstrating that the presence of S. agalactiae negatively influence milk quality [8].
Capsular genotyping has been extensively applied in epidemiological research into S. agalactiae due to the structural diversity of CPS being linked to the genetic multiplicity of the capsular polysaccharide biosynthesis group across various geographic regions [9,10,11,12,13]. The severity of mastitis is primarily determined by the SCC and virulence factors [9]. For example, CPS enables the bacteria to evade the host’s immune defenses. Our previous study reported that the S. agalactiae involved in bovine mastitis in Thailand is CPS type Ia [7]. In Asia, CPS type Ia has been consistently reported as the most common type in Thailand and China [14,15,16]. For instance, a study in Thailand on S. agalactiae variants causing bovine mastitis revealed that 17 isolates were identified as a single CPS type Ia strain with ST 103 [14]. Similarly, in China, among 102 S. agalactiae isolates from subclinical mastitis cases, only two CPS types (Ia and II) were identified, with CPS type Ia being the predominant variant (89%) [16]. The CPS type of S. agalactiae (Group B Streptococcus or GBS) is closely associated with its virulence and pathogenicity. CPS is an important virulence factor that plays a multifaceted role in the bacterium’s ability to cause the invasion, adhesion, and immune evasion of the disease [17]. Furthermore, CPS types are associated with virulence levels. This is the target for vaccine development due to its ability to elicit an immune response against the most prevalent and virulent strains in the target area.
The ability of S. agalactiae to cause bovine mastitis, encompassing the stages of adhesion, invasion, and infection, relies on bacterial virulence factors. Bacterial virulence factors establish infection. Host immunity is responsible for inflammation due to host-pathogen interaction [18]. Bacteria invade the teat canal and cistern during the invasion stage. S. agalactiae colonizes and proliferates in the mammary gland ducts. Virulence factors associated with adhesion and colonization include the immunogenic bacterial adhesion (bibA) and protein C, encompassing surface proteins Cα (bca) and Cβ (bac). Virulence factors contributing to invasion and colonization include fibrinogen-binding protein A (fbsA), fibrinogen-binding protein B (fbsB), pilus island 1 (PI-1), and pilus island 2 (PI-2a, PI-2b). The virulence factor associated with the infection stage is the CAMP factor [11,19]. The CAMP factor (cfb) and β-hemolysin/cytolysin (cyl) are the primary virulence factors affecting the pathogenicity of S. agalactiae [12,17,19]. A CAMP factor is an extracellular protein that induces pore formation in target cells, demonstrated in both in vitro and in vivo systems [20]. The cyl gene, which encodes β-hemolysin, causes tissue damage and the systemic spread of the bacteria [21]. These virulence factors are often used as markers for genotyping and epidemiological studies [11,15,17,22,23]. Furthermore, characterizing virulence factors is crucial for understanding clinically relevant virulence factors.
An understanding of the role of virulence factors in bacterial pathogenicity is important for developing targeted treatments for bovine mastitis. For example, virulence factors, such as adhesins and toxins, are crucial to the bacteria’s ability to adhere to and invade mammary epithelial cells, leading to mastitis development. Consequently, treatment approaches may involve targeting these specific virulence factors to disrupt the pathogenic process.
The treatment goals are to cure the infection and eradicate the source of new infections in dairy herds. Intramammary antimicrobial agents effectively eradicated this contagious pathogen [1]. The current standard approach for treating bovine mastitis caused by S. agalactiae in dairy cows involves the use of antimicrobial agents. Administering intramammary beta-lactam antimicrobials has been proven to be effective in achieving a high rate of recovery [24,25]. The antimicrobial susceptibility profile of S. agalactiae requires regular monitoring. Consequently, it is imperative to conduct antimicrobial susceptibility studies that can facilitate the implementation of rational and appropriate antimicrobial therapy guidelines. This information plays a key role in mitigating the risk of development and spread of antimicrobial resistance (AMR).
AMR in animals has the potential to be transmitted to humans, and this phenomenon is increasingly concerning in the context of public health. This concern underscores the urgent need for comprehensive measures. Individuals working with animals, such as dairy farmers, veterinarians, and animal handlers, may be exposed to AMR-carrying bacteria through direct contact with infected animals [26]. Furthermore, resistant bacteria can persist in the environment [27]. Therefore, regular monitoring and surveillance of AMR in animals are crucial for the measures implemented in the Thai dairy sector.
The aim of this study was to investigate the 10 virulence factors associated with and the antimicrobial susceptibility of S. agalactiae strains from bovine mastitis cases in Thailand. We conducted susceptibility tests for 12 antimicrobial agents commonly used to treat bovine mastitis in dairy cows and other infectious diseases in Thailand. The findings of this study have considerable significance as they offer insights into the field of prevention and control strategies, which can enhance the management of bovine mastitis and promote the responsible use of antimicrobial agents in Thai dairy farms.
2. Materials and Methods
2.1. The Ethical Approval Statement
The protocols employed in this research effort underwent thorough review and received endorsement from the Institutional Biosafety Use Protocol (IBC 1931051) at Chulalongkorn University, Faculty of Veterinary Science.
2.2. Bacterial Isolates and Sample Collection
All, 100 strains of S. agalactiae examined in this study were identified as CPS type Ia, as documented in a preceding investigation [7]. All studied isolates were identified by conventional microbiological methods by the National Mastitis Council (NMC), the VITEK2 system, and a molecular specific dlt S gene. The strains were carefully preserved at −80 °C to facilitate subsequent analyses. The research procedures were carried out in a biosafety level 2 laboratory located at the Livestock Hospital, Faculty of Veterinary Science, Chulalongkorn University, situated in Nakorn Pathom Province, Thailand. From 2016 to 2019, a total of 100 strains of S. agalactiae were isolated from mastitis cases in 58 cows, encompassing those diagnosed with clinical mastitis (n = 21) and subclinical mastitis (n = 37). Clinical mastitis cases underwent assessment by veterinarians through a comprehensive visual examination, including the observation of milk and udder abnormalities (heat, redness, and swelling). Subclinical mastitis was identified through the application of the California Mastitis Test, yielding positive outcomes. Quarter milk culture analysis revealed the presence of S. agalactiae in one quarter (n = 33), two quarters (n = 11), three quarters (n = 11), and all quarters (n = 3) of the cows (refer to Table 1). These mastitis cases occurred among 13 dairy farms situated in the top three most intensive dairy farming provinces including Nakhon Ratchasima (14°58′14.38″ N, 102°06′7.06″ E), Saraburi (14°31′25.79″ N, 100°54′24.59″ E), and Ratchaburi (13°32′12.16″ N, 99°49′1.63″ E).

Table 1.
Characteristics of 100 S. agalactiae strains associated with mastitis type.
The retrieval of strains was conducted from a −80 °C freezer stock in which brain–heart infusion broth with 25% glycerol (Difco™, BBL™ Bacto™) was used as a medium. We employed the culture-based method for recovering studied strains. This technique entails two successive subcultures on sheep blood agar before subsequent testing. In brief, the samples preserved at −80 °C were equilibrated to room temperature. Following this, the samples were plated on blood agar plates using a sterile inoculation loop via the spread plate method. The resultant plates were then incubated in a carbon-dioxide-rich environment at 37 °C overnight. After the incubation period, a singular pure colony was discerned on the plate. Subsequently, it underwent a second round of subculturing, and a sole pure colony was chosen for subsequent detailed analysis.
2.3. Reference Strains
The reference bacterial strains, for the laboratory’s quality control measures, were procured from the American Type Culture Collection (ATCC) through LGC Standards. Staphylococcus aureus ATCC 25923 served both as a control for the CAMP test and as the positive control for the catalase test. Additionally, various strains of S. agalactiae from ATCC, namely ATCC 12400 (CPS type Ia), ATCC 13813 (CPS type II), and ATCC 31475 (CPS type III), were incorporated. All S. agalactiae reference strains were included specifically for the identification of virulence genes.
2.4. Preparation of the DNA Model for Molecular Procedures
The process of DNA extraction was conducted within a level 2 biosafety cabinet. Subsequently, DNA was extracted from the pure culture in accordance with the DNeasy® Blood & Tissue Kit protocol, as stipulated by Qiagen in Hilden, Germany. The concentration and purity of the extracted DNA were evaluated utilizing a spectrophotometer, specifically the Nanodrop™ lite from Thermo Scientific™ in the Massachusetts, U.S.. The extracted DNA, judged suitable, served as the template for all PCR assays. Subsequently, all DNA samples were carefully collected and stored at −20 °C in preparation for subsequent analyses.
2.5. Characterization of Molecular Virulence Factors
Ten virulence genes were determined via singleplex conventional PCR. The virulence factors were bibA, bca, bac, fbsA, fbsB, PI-1, PI-2a, PI-2b, cfb, and cyl. These target genes are associated with S. agalactiae infection. All primer sequences from this study are displayed in Table 2 [14,26,27]. The PCR mix composition comprises 25 µL, incorporating 12.5 µL of 10x Green GoTaq® Flexi Buffer sourced from PROMEGA in Madison, WI, USA. Additionally, the mixture includes 1 µL [10.0 µM] of the forward primer, 1 µL [10.0 µM] of the reverse primer, 2 µL of the DNA template, and 8.5 µL of Nuclease Free Water. PCR mixtures were amplified using a T100 Thermal Cycler (Biorad®, California, U.S.) starting with a 5 min initial denaturation step at 95 °C, followed by 35 cycles of 1 min at 95 °C, 1 min at 55 °C, and 2 min at 72 °C, concluding with a final extension cycle of 5 min at 72 °C.

Table 2.
The list of primers used to determine virulence factors; data from [15,29,30].
2.6. Antimicrobial Susceptibility of S. agalactiae Strains
The antimicrobial susceptibility test was conducted using the agar Kirby–Bauer disk diffusion susceptibility method following the guidelines of the VET 01 supplement [31] from the Clinical and Laboratory Standards Institute. The CLSI VET01 outlines performance standards for antimicrobial disks and dilution susceptibility tests for bacteria isolated from animals. Twelve antimicrobials (7 classes) were selected for their use in treating bovine diseases in Thailand.
The antimicrobial disks utilized in this study included ampicillin (10 µg), amoxicillin + clavulanic acid (30 µg), cefotaxime (30 µg), ceftiofur (30 µg), gentamicin (10 µg), kanamycin (30 µg), tetracycline (30 µg), erythromycin (15 µg), enrofloxacin (5 µg), penicillin (10 µg), sulfamethoxazole-trimethoprim (25 µg), and vancomycin (30 µg), which were obtained as commercial Oxoid™ disks. The Streptococcus pneumoniae ATCC 49619 strain is used as a reference control strain.
The diameters of the zones among the isolates were measured and recorded. The diameters of the inhibition zones were classified as susceptible, resistant, and intermediate according to the breakpoint diameter standard. We applied breakpoints from other animals or other Streptococcus species (CLSI, 2019). The susceptibility percentage to an individual antimicrobial was calculated. If the isolate was resistant to three or more antimicrobial classes, the strain was defined as multidrug-resistant (MDR) [32].
2.7. Statistical Analysis
The association between the types of mastitis (clinical and subclinical) and the presence of virulence gene categories was determined using the chi-square test. A p value of <0.05 was considered statistically significant.
3. Results
All S. agalactiae were previously identified using the conventional microbiological method by NMC, with a VITEK2 system, and a dlt S gene-specific molecular test [7]. All strains of S. agalactiae collected from 2016 and 2019 were identified based on colony morphology, hemolysis type, esculin hydrolysis, catalase production, and CAMP reaction. To characterize the strains, their phenotypic traits were assessed, encompassing colony growth evaluation and β-hemolysis observation on blood agar (n = 88). The remaining 12 isolates were tested for alpha-hemolysis (Figure 1). Furthermore, all tested strains yielded positive results in the CAMP test, while the esculin hydrolysis and catalase tests were negative. These findings collectively enhance the comprehensive understanding of the phenotypic properties and virulence factor profiles of β-hemolysin (cyl).

Figure 1.
Hemolytic phenotype activity of S. agalactiae field strains. (A) shows β hemolysis (n = 88), (B) shows α hemolysis (n = 12).
3.1. Molecular Characterization of Virulence Factors
We examined 10 virulence factors. The bibA, cfb, and fbsB genes were present in all the strains. The prevalence rates of fbsA, cyl, and PI-2B were 98%, 97%, and 53%, respectively. However, the bca, bac, PI-1, and PI-2a genes were not detected in this study (Table 3). According to hemolytic activity, the cyl β-hemolysin/cytolysin gene was identified in 97% of the strains studied, while 88% of the strains exhibited β-hemolysis on blood agar.

Table 3.
The presence of virulence factor profiles in Streptococcus agalactiae strains causing bovine mastitis.
The presence of virulence factors was classified into five virulence profiles. It is crucial to emphasize that all profiles exhibit at least one virulence factor associated with invasion, adhesion, or infection, which initiates intramammary infection leading to bovine mastitis. The first major virulence profile includes cfb, cyl, fbsA, fbsB, PI-2b, and bibA, which were identified in 13 herds (n = 51). The second major profile consists of cfb, cyl, fbsA, fbsB, and bibA, identified in 13 herds (n = 45) (Table 3).
However, the presence of the virulence factors did not show a statistically significant association with the type of mastitis (clinical and subclinical).
3.2. Antimicrobial Susceptibility Profiles
Antimicrobial susceptibility was interpreted according to the CLSI VET 08 breakpoint zone diameter standard. S. agalactiae strains showed susceptibility to penicillin (95%), ampicillin (95%), amoxicillin-clavulanic acid (100%), cefotaxime (98%), ceftiofur (100%), erythromycin (99%), enrofloxacin (44%), sulfamethoxazole-trimethoprim (92%), tetracycline (68%), and vancomycin (96%). However, our collection exhibited an intermediate level of susceptibility to enrofloxacin (56%). All S. agalactiae strains were resistant to kanamycin (100%) and gentamicin (100%) (Figure 2).

Figure 2.
Antimicrobial susceptibility profile of S. agalactiae (n = 100). Abbreviations: P: penicillin; AMP: ampicillin; AMC: amoxicillin; CTX: cefotaxime; CTF: ceftiofur; K: kanamycin; CN: gentamicin; E: erythromycin; EFX: enrofloxacin; SXT: sulfamethoxazole-trimethoprim; TET: tetracycline and VAN: vancomycin.
We identified seven strains exhibiting multidrug resistance (MDR) profiles, including resistance to aminoglycosides, quinolones, tetracycline, beta-lactams, and glycopeptides (Table 4). At least four MDR profiles have been categorized. These four MDR profiles were found in only two virulence factor profiles (A and B).

Table 4.
Multidrug-resistant S. agalactiae profiles.
The first MDR profile of S. agalactiae was from herd F, which was one of the eighteen strains (5.55%). This strain is resistant to five antimicrobials (penicillin, ampicillin, kanamycin, gentamicin, and sulfamethoxazole-trimethoprim). The second MDR S. agalactiae profile comprised four strains from three herds. The MDR strains included one from herd C (100%), one from herd D (11.11%), and two strains from herd K (50%). These strains are resistant to four antimicrobials (kanamycin, gentamicin, sulfamethoxazole-trimethoprim, and tetracycline). The third MDR profile of S. agalactiae was identified in herd D, which was one of the nine strains (11.11%). This strain is resistant to four antimicrobials (kanamycin, gentamicin, tetracycline, and vancomycin). The last MDR profile of S. agalactiae was also identified in herd D, which was one of the nine strains (11.11%). This strain is resistant to four antimicrobials (kanamycin, gentamicin, erythromycin, and vancomycin). It is important to highlight that herd D had three different MDR strains of S. agalactiae. We also identified two vancomycin-resistant strains of S. agalactiae with MDR profiles causing bovine mastitis in herd D.
4. Discussion
Bovine mastitis caused by S. agalactiae is a major veterinary and dairy farmer issues globally [1,13]. It is responsible for one of the main types of contagious mastitis in dairy farms [33]. The infection typically spreads from cow to cow during milking. The infected cow is the primary source of infection within the herd. In this study, we identified the virulence factor profiles and antimicrobial susceptibility of S. agalactiae causing bovine mastitis in Thailand’s intensive dairy production area.
This study investigated virulence factors related to pathogenicity, including the ability to adhere, invade host cells, and establish an infection in the mammary gland. It is important to highlight that we detected the virulence factors bibA, fbsB, and cfb in all S. agalactiae strains. The analysis of virulence factors revealed that the majority of the strains (96%) amplified the following virulence genes: fbsA, fbsB, bibA, cfb, and cyl, which play a role in the stages of intramammary infection caused by S. agalactiae, such as adhesion (bibA), invasion and colonization (fbsA and fbsB), and infection (cfb and cyl).
As for the adhesion, invasion, and colonization stages, our study found that all strains harbored bibA and fbsB genes. The fbsA gene was identified in most strains (98%). Our findings align with a previous study indicating that all bovine mastitis strains caused by S. agalactiae were positive for bibA [10,16] and fbsB [23]. The fbsA gene was identified in 92.6% of S. agalactiae isolates from dairy herds in Poland [23]. The bibA, fbsA, and fbsB genes are involved in the adhesion and invasion mechanisms of the pathogen in the mammary gland, which facilitates the attachment of S. agalactiae to mammary epithelial cells. The ability of bacterial cells to adhere is the most important mechanism for the successful colonization of mammary tissue. This mechanism enables bacteria to effectively neutralize the continuous flow of milk and establish a persistent presence in the bovine mammary gland [15]. This prolonged colonization may ultimately contribute to the development of chronic and subclinical mastitis [23]. Our study did not identify any associations between individual virulence factors and virulence profiles associated with types of mastitis (clinical and subclinical).
Thus, the cyl gene serves as a valuable marker for identifying and investigating the pathogenic potential of S. agalactiae in the context of infections. Several studies have confirmed the presence of this factor in all tested strains of both clinical and subclinical mastitis [15,34]. Furthermore, they are involved in the recruitment of various cytotoxic and pro-inflammatory cytokines, leading to the recruitment of neutrophils that cause tissue damage [21].
The study investigated hemolytic virulence by examining both the cyl gene and phenotypic hemolysis. Most S. agalactiae strains carried the cyl gene, at 97%, while 88% of the strains exhibited β-hemolysis on blood agar. These findings are consistent with a previous study indicating that 95.6% of S. agalactiae isolates were positive for the cyl gene, and 89.7% exhibited β-hemolysis [23]. The cyl gene encodes the cytolysin enzyme, a key factor in the hemolytic activity of group B streptococci [12,19]. The production of cytolysin leads to the lysis of red blood cells, resulting in the characteristic pattern of beta-hemolysis observed on blood agar. It is important to emphasize that all β-hemolytic strains in this study were consistently associated with the presence of the cyl gene. These findings support the presence of a strong correlation between gene expression and hemolysis. The remaining nine strains, despite harboring the cyl gene, did not exhibit β-hemolysis, which could be attributed to the lack of gene expression [19,23]. Certain Group B streptococci exhibit beta-hemolysis and harbor the entire cyl gene cluster, while other strains show no hemolysis and have mutations in the cyl locus [35,36].
The cfb gene encodes the CAMP factor, which promotes hemolysis. Notably, the cfb gene was detected in all strains in this study, which is consistent with other research [37,38]. Functionally, this gene forms pores in the host’s cell membrane and binds to glycosylphosphatidylinositol (GPI)-anchored proteins, leading to the subsequent impairment of the host’s immune function [12,19,39]. Previous studies suggest that the CAMP factor toxin plays a significant role in S. agalactiae infection [20,23].
Our study categorized a significant proportion of strains (51%) that displayed specific virulence gene profiles, including cfb, cyl, fbsA, fbsB, PI-2b, and bibA (Table 3). Furthermore, our analysis revealed that 45% of the strains exhibited a virulence gene pattern comprising cfb, cyl, fbsA, fbsB, and bibA, while concurrently lacking the PI-2b gene. The presence of PI-1, PI-2a, and PI-2b in S. agalactiae is known to facilitate processes such as adherence, invasion, and immune evasion [19]. Notably, research into PI-2b has revealed its strong capacity for adherence and biofilm formation in bovine strains. This evidence supports the capability of S. agalactiae to adhere to the host cell [15]. This study did not detect strains with PI-1, PI-2a, bac, and bca, consistent with other research on S. agalactiae isolated from clinical and subclinical bovine mastitis [11,22,34,40]. The bac and bca genes encode surface molecules that mediate adhesion to host cells. In humans, it has also been reported as a key factor in the invasion of human cervical epithelial cells [41].
In further studies, we aim to prioritize the selection of CPS serotype Ia exhibiting a virulent profile consisting of cfb, fbsB, and bibA genes. This selection is intended for rapid diagnosis and as a primary target in the development of candidate vaccines. These profiles have all of the virulence factors which are essential for establishing mastitis infection and match all strains we examined in specific regions of Thailand. Further research is required to fully assess the effectiveness of vaccine implementation in the future. This study did not show the relationship between the virulence profiles and MDR profiles. However, virulence profile B is the only profile showing vancomycin resistance.
Antimicrobial treatment is recommended for S. agalactiae causing bovine mastitis [42]. In our study, we assessed the susceptibility of the S. agalactiae strains to 12 different antimicrobials using the Kirby–Bauer disk diffusion susceptibility test. Our findings revealed varying degrees of susceptibility among the strains. Our S. agalactiae strains are predominantly susceptible to beta-lactam antibiotics (95–100%), including penicillin, ampicillin, cefotaxime, and ceftiofur. These findings align with a prior study in Brazil [43] and a study on of S. agalactiae in clinical bovine mastitis isolates from Denmark, which demonstrated full susceptibility to penicillin in all isolates [44]. In contrast, studies in China have reported significantly higher resistance rates to beta-lactam drugs in cases of bovine mastitis caused by S. agalactiae [45,46]. Important, a previous report has shown that the dissemination of these resistant pathogens in both humans and animals, along with potential environmental contamination caused by the utilization of manure as fertilizer, is associated with an increased global risk. Hence, a one health perspective is important [47,48]. These inconsistent findings may reflect the clinical use of antimicrobials across geographic regions. Nevertheless, penicillin and ampicillin remain the preferred treatment options for S. agalactiae which cause bovine mastitis, particularly in our study area.
In Thailand, antimicrobial drugs are extensively employed to address prevalent infectious diseases as part of common therapeutic practices. For example, the treatment of bacterial complications associated with foot-and-mouth disease [49], respiratory infections, such as bovine respiratory disease complex [50], reproductive tract disorders, and mastitis are among the diverse array of health challenges encountered in cattle. In the case of mastitis, the intramammary antimicrobial drugs which can be used include penicillin, ampicillin, cloxacillin, gentamicin, cephalothin, cefuroxime, and ceftiofur. All S. agalactiae strains were resistant to kanamycin and gentamicin. These findings align with a study from Northern Italy, wherein S. agalactiae isolates from humans and cattle exhibited resistance to aminoglycosides [51]. Furthermore, other studies have shown high resistance rate (93.3–100%) to kanamycin and gentamicin in clinical bovine mastitis isolates [24,52]. The aminoglycoside resistance mechanism in S. agalactiae remains poorly understood. Overall, aminoglycoside resistance encompasses various mechanisms, such as enzymatic modification, target site alteration through enzymatic action or chromosomal mutation, and efflux mechanisms [53]. Enzymatic modification is often found in plasmids harboring multiple resistance elements, including additional enzymatic modifications of aminoglycosides [54]. This is influenced by the selective pressure exerted by the excessive or improper use of these antimicrobials, which varies according to the geographic area of specific aminoglycoside use [55]. High rates of gentamicin resistance in Group B Streptococcus also result in the loss of a synergistic effect on susceptibility to beta-lactam treatment [56].
In this study, 56% of S. agalactiae strains exhibited intermediate susceptibility to enrofloxacin. A prolonged course of treatment and dosage adjustment is required. Other studies have reported evidence of quinolone resistance in China [46], Croatia [57], and Slovakia [58]. However, it is important to note that quinolone resistance is acquired through the accumulation of various resistance mechanisms within a single bacterial strain and can be transferred to others [59].
In this study, 32% of S. agalactiae strains are resistant to tetracycline. In a previous study, high resistance rates (95%) to tetracycline were reported in S. agalactiae strains isolated from bovine mastitis [60]. These findings are consistent with other research on antimicrobial susceptibility, showing that S. agalactiae is typically susceptible to a range of antimicrobials, with the exception of tetracycline [11,25]. Tetracycline resistance has been confirmed to frequently involve the presence of resistance genes among bovine isolates, which are disseminated through horizontal gene transfer within the same genus [61,62]. The resistance genes, which can be carried on mobile genetic elements such as plasmids or transposons, allow them to protect ribosomes from the inhibitory effects of tetracycline. The global decline in tetracycline efficacy is likely due to its past overuse, including in non-targeted treatments [52].
Interestingly, our study revealed that seven MDR S. agalactiae strains occurred in four dairy herds. In particular, herd D, we were able to detect three strains (33.33%; 3/9 strains) with different MDR profiles of S. agalactiae. The MDR profiles of S. agalactiae varied across antimicrobial groups. This is the first evidence of MDR S. agalactiae causing bovine mastitis in Thai dairy farms. The previous study on two human strains of S. agalactiae resistant to vancomycin was first reported in 2014 [63]. The high prevalence of vancomycin-resistant S. agalactiae causing bovine mastitis has been reported in small dairy farms in Turkey [64]. However, our study indicated that only 2% (2/100 strains) of S. agalactiae are resistant to vancomycin. These two strains are present among our seven MDR strains, which were identified in herd D.
The common antimicrobials used in Thai dairy farms include aminoglycoside (gentamicin and kanamycin), quinolones (enrofloxacin), tetracycline, sulfonamides (sulfamethoxazole-trimethoprim), and beta-lactams (penicillin and ampicillin). These agents are widely used for the treatment of infectious diseases in dairy cattle in Thailand, including bacterial complications from foot-and-mouth disease [49], respiratory infections such as bovine respiratory disease complex [50], gastrointestinal infections, blood parasite infections, reproductive tract infections, and mastitis. Our findings may raise awareness and concerns regarding the routine use of antimicrobials on dairy farms. This incidence of MDR S. agalactiae may pose a global public health risk [65]. This study provides new insights into MDR S. agalactiae causing bovine mastitis in Thailand. Furthermore, our study underscores the critical importance of ongoing surveillance of S. agalactiae to find epidemiological patterns and antimicrobial susceptibility, in conjunction with global research on the emerging trends of MDR GBS isolates.
Extensive use of antimicrobials on dairy farms likely contributes to their high prevalence of AMR [66]. Over 50% of antimicrobial agents used in treating bovine mastitis led to excessive and unnecessary economic losses for dairy farms [67]. Furthermore, this treatment practice carries the risk of fostering the emergence of bacterial resistance and antimicrobial residues in milk [68]. They pose a threat not only to human health but also to the environment as pollution [45]. The incidence of MDR in this study encourages farmers, veterinarians, consumers, and policymakers to prioritize the rational use of antimicrobials to minimize the risk of MDR emergence in animals and humans.
It is essential to identify, characterize, and monitor AMR in bacterial pathogens using classical microbiological and molecular approaches. The comparison between human and bovine-derived strains [2] should be more interested in order to investigate the linkage transmission profiles of these agents [2,69,70,71]. Further genotypic study of the AMR resistance gene enhances our understanding of the mechanics and epidemiology of AMR. It also serves as a guide for treatment decisions and infection control strategies. Accountability for the use of antimicrobials in animals and adhering to proper guidelines and regulations to minimize unnecessary antimicrobial use are urgently required. Improving milking hygiene and sanitation practices may enhance efforts to the spread of this pathogen and decrease antimicrobial usage.
5. Conclusions
The study on the characteristics of Thai strains of S. agalactiae causing bovine mastitis updates our understanding of this contagious mastitis pathogen. We found that all strains have at least three virulence factors (bibA, fbsB, and cfb) which are implicated in adhesion, invasion, and the intramammary infection stages during mastitis establishment. These findings aid in the advancement of bovine mastitis prevention and control strategies, encompassing vaccine development prospects. The beta-lactam antimicrobial class is effectively used in treating cows infected with S. agalactiae. MDR strains of S. agalactiae associated with bovine mastitis have been identified in our region. Antimicrobial susceptibility profile monitoring should be conducted regularly. The rise in AMR among bovine strains of S. agalactiae calls for significant concern and comprehensive integrated measures regarding the justified use of antimicrobials on Thai dairy farms.
Author Contributions
Conceptualization, K.A. and S.W.; methodology, S.W. and S.S.; Writing—Original draft preparation, K.A. and S.W.; Writing—Review and editing, S.W., T.B. and K.A. All authors have read and agreed to the published version of the manuscript.
Funding
This study was supported by the 100th Anniversary of Chulalongkorn University.
Institutional Review Board Statement
All procedures of this project have been reviewed and approved by the Institutional Biosafety Use Protocol [Chulalongkorn University, Faculty of Veterinary Science] No. IBC 1931051; 20 February 2021.
Informed Consent Statement
Not applicable.
Data Availability Statement
The data presented in this study are available on reasonable request from the corresponding author.
Acknowledgments
The authors extend their gratitude to the veterinarians and farmers who contributed to the milk sample collection in our study. We acknowledge the support for research facilities provided by the Tropical Dairy Research Center (TDRC) Saraburi province, Faculty of Veterinary Science, Chulalongkorn University.
Conflicts of Interest
The authors declare no conflicts of interest. The funders did not play any role in the study design, data collection, analysis, interpretation, manuscript writing, or the decision to publish the results.
References
- Keefe, G. Update on control of Staphylococcus aureus and Streptococcus agalactiae for management of mastitis. Vet. Clin. N. Am. Food A Food Anim. Pract. 2012, 28, 203–216. [Google Scholar] [CrossRef]
- Reyes, J.; Chaffer, M.; Rodriguez-Lecompte, J.C.; Sánchez, J.; Zadoks, R.N.; Robinson, N.; Cardona, X.; Ramírez, N.; Keefe, G. Molecular epidemiology of Streptococcus agalactiae differs between countries. J. Dairy Sci. 2017, 100, 9294–9297. [Google Scholar] [CrossRef]
- Reyes, J.; Chaffer, M.; Sanchez, J.; Torres, G.; Macias, D.; Jaramillo, M.; Duque, P.; Ceballos, A.; Keefe, G. Evaluation of the efficacy of intramuscular versus intramammary treatment of subclinical Streptococcus agalactiae mastitis in dairy cows in Colombia. J. Dairy Sci. 2015, 98, 5294–5303. [Google Scholar] [CrossRef]
- Holmøy, I.H.; Toft, N.; Jørgensen, H.J.; Mørk, T.; Sølverød, L.; Nødtvedt, A. Latent class analysis of real time qPCR and bacteriological culturing for the diagnosis of Streptococcus agalactiae in cow composite milk samples. Prev. Vet. Med. 2018, 154, 119–123. [Google Scholar] [CrossRef]
- Boonyayatra, S.; Thaboonpeng, J.; Kreausukon, K.; Suriyasathaporn, W. Anitimicrobial resistance of mastitis associated bacteria in lactating dairy cows in chiang mai province. Chiang Mai Vet. J. 2007, 5, 135–145. [Google Scholar]
- Kampa, J.; Sukolapong, V.; Buttasri, A.; Charoenchai, A. Prevalence of Mycoplasma bovis and other contagious bovine mastitis pathogens in bulk tank milk of dairy cattle herds in Khon Kaen Province, Thailand. Thai J. Vet. Med. 2009, 39, 275–280. [Google Scholar] [CrossRef]
- Wataradee, S.; Samngamnim, S.; Boonserm, T.; Ajariyakhajorn, K. Genotypic and antimicrobial susceptibility of Streptococcus agalactiae causing bovine mastitis in the central region of Thailand. Front. Vet. Sci 2023, 10, 1250436. [Google Scholar] [CrossRef] [PubMed]
- Mesquita, A.A.; Rocha, C.M.; Bruhn, F.R.; Custódio, D.A.; Braz, M.S.; Pinto, S.M.; Silva, D.B.; Costa, G.M. Staphylococcus aureus and Streptococcus agalactiae: Prevalence, resistance to antimicrobials, and their relationship with the milk quality of dairy cattle herds in Minas Gerais state, Brazil. Pesqui. Veterinária Bras. 2019, 39, 308–316. [Google Scholar] [CrossRef]
- Chaffin, D.O.; Beres, S.B.; Yim, H.H.; Rubens, C.E. The serotype of type Ia and III group B streptococci is determined by the polymerase gene within the polycistronic capsule operon. J. Bacteriol. 2000, 182, 4466–4477. [Google Scholar] [CrossRef]
- Heath, P.T. Status of vaccine research and development of vaccines for GBS. Vaccine 2016, 34, 2876–2879. [Google Scholar] [CrossRef] [PubMed]
- Carvalho-Castro, G.A.; Silva, J.R.; Paiva, L.V.; Custódio, D.A.C.; Moreira, R.O.; Mian, G.F.; Prado, I.A.; Chalfun-Junior, A.; Costa, G.M. Molecular epidemiology of Streptococcus agalactiae isolated from mastitis in Brazilian dairy herds. Braz. J. Microbiol. 2017, 48, 551–559. [Google Scholar] [CrossRef] [PubMed]
- Shabayek, S.; Spellerberg, B. Group B streptococcal colonization, molecular characteristics, and epidemiology. Front. Microbiol. 2018, 9, 437. [Google Scholar] [CrossRef] [PubMed]
- Zadoks, R.N.; Schukken, Y.H. Use of molecular epidemiology in veterinary practice. Vet. Clin. N. Am. Food A Food Anim. Pract. 2006, 22, 229–261. [Google Scholar] [CrossRef] [PubMed]
- Boonyayatra, S.; Wongsathein, D.; Tharavichitkul, P. Genetic relatedness among Streptococcus agalactiae isolated from Cattle, Fish, and Humans. Foodborne Pathog. Dis. 2020, 17, 137–143. [Google Scholar] [CrossRef] [PubMed]
- Pang, M.; Sun, L.; He, T.; Bao, H.; Zhang, L.; Zhou, Y.; Zhang, H.; Wei, R.; Liu, Y.; Wang, R. Molecular and virulence characterization of highly prevalent Streptococcus agalactiae circulated in bovine dairy herds. Vet. Res. 2017, 48, 65. [Google Scholar] [CrossRef]
- Yang, Y.; Liu, Y.; Ding, Y.; Yi, L.; Ma, Z.; Fan, H.; Lu, C. Molecular characterization of Streptococcus agalactiae isolated from bovine mastitis in Eastern China. PLoS ONE 2013, 8, 67755. [Google Scholar] [CrossRef]
- Lin, L.; Huang, X.; Yang, H.; He, Y.; He, X.; Huang, J.; Li, S.; Wang, X.; Tang, S.; Liu, G. Molecular epidemiology, antimicrobial activity, and virulence gene clustering of Streptococcus agalactiae isolated from dairy cattle with mastitis in China. J. Dairy Sci. 2021, 104, 4893–4903. [Google Scholar] [CrossRef]
- Kulkarni, A.G.; Kaliwal, B. Bovine mastitis: A review. Int. J Recent Sci. 2013, 4, 543–548. [Google Scholar]
- Rajagopal, L. Understanding the regulation of Group B Streptococcal virulence factors. Future Microbiol. 2009, 4, 201–221. [Google Scholar] [CrossRef]
- Hensler, M.E.; Quach, D.; Hsieh, C.-J.; Doran, K.S.; Nizet, V. CAMP factor is not essential for systemic virulence of Group B Streptococcus. Microb. Pathog. 2008, 44, 84–88. [Google Scholar] [CrossRef]
- Doran, K.S.; Liu, G.Y.; Nizet, V. Group B streptococcal β-hemolysin/cytolysin activates neutrophil signaling pathways in brain endothelium and contributes to development of meningitis. J. Clin. Investig. 2003, 112, 736–744. [Google Scholar] [CrossRef]
- Emaneini, M.; Jabalameli, F.; Abani, S.; Dabiri, H.; Beigverdi, R. Comparison of virulence factors and capsular types of Streptococcus agalactiae isolated from human and bovine infections. Microb. Pathog. 2016, 91, 1–4. [Google Scholar] [CrossRef]
- Zastempowska, E.; Twarużek, M.; Grajewski, J.; Lassa, H. Virulence Factor Genes and Cytotoxicity of Streptococcus agalactiae Isolated from Bovine Mastitis in Poland. Microbiol. Spectr. 2022, 10, e0222421. [Google Scholar] [CrossRef] [PubMed]
- Kaczorek, E.; Małaczewska, J.; Wójcik, R.; Rękawek, W.; Siwicki, A. Phenotypic and genotypic antimicrobial susceptibility pattern of Streptococcus spp. isolated from cases of clinical mastitis in dairy cattle in Poland. J. Dairy Sci. 2017, 100, 6442–6453. [Google Scholar] [CrossRef]
- Tomazi, T.; de Souza Filho, A.F.; Heinemann, M.B.; dos Santos, M.V. Molecular characterization and antimicrobial susceptibility pattern of Streptococcus agalactiae isolated from clinical mastitis in dairy cattle. PLoS ONE 2018, 13, e0199561. [Google Scholar] [CrossRef]
- Lechner, I.; Freivogel, C.; Stärk, K.D.; Visschers, V.H. Exposure pathways to antimicrobial resistance at the human-animal interface—A qualitative comparison of Swiss expert and consumer opinions. Front. Public Health 2020, 8, 345. [Google Scholar] [CrossRef]
- Serwecińska, L. Antimicrobials and antibiotic-resistant bacteria: A risk to the environment and to public health. Water 2020, 12, 3313. [Google Scholar] [CrossRef]
- Koonawootrittriron, S.; Elzo, M. Challenges and opportunities for improvement in dairy production and genetic progress in Thailand. In Proceedings of the 14th AAAP Animal Science Congress, Pingtung, Taiwan, China, 23–27 August 2010; pp. 389–394. [Google Scholar]
- Kayansamruaj, P.; Pirarat, N.; Katagiri, T.; Hirono, I.; Rodkhum, C. Molecular characterization and virulence gene profiling of pathogenic Streptococcus agalactiae populations from tilapia (Oreochromis sp.) farms in Thailand. J. Vet. Diagn. Investig. 2014, 26, 488–495. [Google Scholar] [CrossRef]
- Firon, A.; Tazi, A.; Da Cunha, V.; Brinster, S.; Sauvage, E.; Dramsi, S.; Golenbock, D.T.; Glaser, P.; Poyart, C.; Trieu-Cuot, P. The Abi-domain protein Abx1 interacts with the CovS histidine kinase to control virulence gene expression in group B Streptococcus. PLoS Pathog. 2013, 9, e1003179. [Google Scholar] [CrossRef]
- CLSI. Performance Standards for Antimicrobial Susceptibility Testing; CLSI: Wayne, PA, USA, 2019. [Google Scholar]
- Sweeney, M.T.; Lubbers, B.V.; Schwarz, S.; Watts, J.L. Applying definitions for multidrug resistance, extensive drug resistance and pandrug resistance to clinically significant livestock and companion animal bacterial pathogens. J. Antimicrob. Chemother. 2018, 73, 1460–1463. [Google Scholar] [CrossRef]
- Olde Riekerink, R.G.M.; Barkema, H.W.; Veenstra, S.; Poole, D.E.; Dingwell, R.T.; Keefe, G.P. Prevalence of contagious mastitis pathogens in bulk tank milk in Prince Edward Island. Can. Vet. J. 2006, 47, 567–572. [Google Scholar] [PubMed]
- Hernandez, L.; Bottini, E.; Cadona, J.; Cacciato, C.; Monteavaro, C.; Bustamante, A.; Sanso, A.M. Multidrug resistance and molecular characterization of Streptococcus agalactiae isolates from dairy cattle with mastitis. Front. Cell. Infect. Microbiol. 2021, 11, 647324. [Google Scholar] [CrossRef]
- Liu, G.; Zhang, W.; Lu, C. Comparative genomics analysis of Streptococcus agalactiae reveals that isolates from cultured tilapia in China are closely related to the human strain A909. BMC Genom. 2013, 14, 775. [Google Scholar] [CrossRef]
- Rosa-Fraile, M.; Dramsi, S.; Spellerberg, B. Group B streptococcal haemolysin and pigment, a tale of twins. FEMS Microbiol. Rev. 2014, 38, 932–946. [Google Scholar] [CrossRef] [PubMed]
- Ke, D.; Ménard, C.; Picard, F.J.; Boissinot, M.; Ouellette, M.; Roy, P.H.; Bergeron, M.G. Development of Conventional and Real-Time PCR Assays for the Rapid Detection of Group B Streptococci. Clin. Chem. 2000, 46, 324–331. [Google Scholar] [CrossRef]
- Guo, D.; Xi, Y.; Wang, S.; Wang, Z. Is a positive Christie-Atkinson-Munch-Peterson (CAMP) test sensitive enough for the identification of Streptococcus agalactiae? BMC Infect. Dis. 2019, 19, 7. [Google Scholar] [CrossRef]
- Lasagno, M.C.; Reinoso, E.B.; Dieser, S.A.; Calvinho, L.F.; Buzzola, F.; Vissio, C.; Bogni, C.I.; Odierno, L.M. Phenotypic and genotypic characterization of Streptococcus uberis isolated from bovine subclinical mastitis in Argentinean dairy farms. Rev. Argent. Microbiol. 2011, 43, 212–217. [Google Scholar] [CrossRef]
- Duarte, R.S.; Miranda, O.P.; Bellei, B.C.; Brito, M.A.V.P.; Teixeira, L.M. Phenotypic and Molecular Characteristics of Streptococcus agalactiae Isolates Recovered from Milk of Dairy Cows in Brazil. J. Clin. Microbiol. 2004, 42, 4214. [Google Scholar] [CrossRef] [PubMed]
- Baron, M.J.; Filman, D.J.; Prophete, G.A.; Hogle, J.M.; Madoff, L.C. Identification of a glycosaminoglycan binding region of the alpha C protein that mediates entry of group B streptococci into host cells. J. Biol. Chem. 2007, 282, 10526–10536. [Google Scholar] [CrossRef]
- Kabelitz, T.; Aubry, E.; van Vorst, K.; Amon, T.; Fulde, M. The role of Streptococcus spp. in bovine mastitis. Microorganisms 2021, 9, 1497. [Google Scholar] [CrossRef]
- da Costa, G.M.; Ribeiro, N.A.; Gonçalves, M.S.; da Silva, J.R.; da Costa Custódio, D.A.; Mian, G.F. Antimicrobial susceptibility profile of Streptococcus agalactiae strains isolated from bovine mastitis. Braz. J. Vet. Res. Anim. Sci. 2021, 58, e178109. [Google Scholar] [CrossRef]
- Chehabi, C.N.; Nonnemann, B.; Astrup, L.B.; Farre, M.; Pedersen, K. In vitro antimicrobial resistance of causative agents to clinical mastitis in Danish dairy cows. Foodborne Pathog. Dis. 2019, 16, 562–572. [Google Scholar] [CrossRef] [PubMed]
- Han, G.; Zhang, B.; Luo, Z.; Lu, B.; Luo, Z.; Zhang, J.; Wang, Y.; Luo, Y.; Yang, Z.; Shen, L. Molecular typing and prevalence of antibiotic resistance and virulence genes in Streptococcus agalactiae isolated from Chinese dairy cows with clinical mastitis. PLoS ONE 2022, 17, e0268262. [Google Scholar] [CrossRef] [PubMed]
- Tian, X.; Zheng, N.; Han, R.; Ho, H.; Wang, J.; Wang, Y.; Wang, S.; Li, H.; Liu, H.; Yu, Z. Antimicrobial resistance and virulence genes of Streptococcus isolated from dairy cows with mastitis in China. Microb. Pathog. 2019, 131, 33–39. [Google Scholar] [CrossRef] [PubMed]
- Dogan, B.; Schukken, Y.; Santisteban, C.; Boor, K.J. Distribution of serotypes and antimicrobial resistance genes among Streptococcus agalactiae isolates from bovine and human hosts. J. Clin. Microbiol. 2005, 43, 5899–5906. [Google Scholar] [CrossRef] [PubMed]
- Meroni, G.; Sora, V.M.; Martino, P.A.; Sbernini, A.; Laterza, G.; Zaghen, F.; Soggiu, A.; Zecconi, A. Epidemiology of antimicrobial resistance genes in Streptococcus agalactiae sequences from a public database in a One Health perspective. Antibiotics 2022, 11, 1236. [Google Scholar] [CrossRef] [PubMed]
- Premashthira, S. Overview of Foot and Mouth Disease Control in Thailand and Southeast Asia. In Proceedings of the 20th FAVA & the 15th KIVNAS PDHI, Bali, Indonesia, 1–3 November 2018. [Google Scholar]
- Ajariyakhajorn, K.; Boonserm, T.; Samngamnim, S. Detection of Pathogens Associated with Bovine Respiratory Disease: Clinical Cases in Thai Dairy Herds. In Proceedings of the 20th FAVA & the 15th KIVNAS PDHI, Bali, Indonesia, 1–3 November 2018. [Google Scholar]
- Carra, E.; Russo, S.; Micheli, A.; Garbarino, C.; Ricchi, M.; Bergamini, F.; Bassi, P.; Prosperi, A.; Piva, S.; Cricca, M. Evidence of common isolates of Streptococcus agalactiae in bovines and humans in Emilia Romagna region (Northern Italy). Front. Microbiol. 2021, 12, 673126. [Google Scholar] [CrossRef] [PubMed]
- Rato, M.G.; Bexiga, R.; Florindo, C.; Cavaco, L.M.; Vilela, C.L.; Santos-Sanches, I. Antimicrobial resistance and molecular epidemiology of streptococci from bovine mastitis. Vet. Microbiol. 2013, 161, 286–294. [Google Scholar] [CrossRef]
- Krause, K.M.; Serio, A.W.; Kane, T.R.; Connolly, L.E. Aminoglycosides: An overview. Cold Spring Harb. Perspect. 2016, 6, a027029. [Google Scholar] [CrossRef]
- Magnet, S.; Blanchard, J.S. Molecular insights into aminoglycoside action and resistance. Chem. Rev. 2005, 105, 477–498. [Google Scholar] [CrossRef]
- Tenover, F.C. Mechanisms of antimicrobial resistance in bacteria. Am. J. Med. 2006, 119, S3–S10. [Google Scholar] [CrossRef]
- Sendi, P.; Furitsch, M.; Mauerer, S.; Florindo, C.; Kahl, B.C.; Shabayek, S.; Berner, R.; Spellerberg, B. Chromosomally and extrachromosomally mediated high-level gentamicin resistance in Streptococcus agalactiae. Antimicrob. Agents Chemother. 2016, 60, 1702–1707. [Google Scholar] [CrossRef]
- Sukalić, T.; Đuričić, D.; Pavljak, I.; Končurat, A.; Cvetnić, Ž.; Grbavac, J.; Bačanek, B.; Jurmanović, J.; Samardžija, M. Antimicrobial susceptibility of bovine mastitis pathogens from northwestern Croatia in the period 2014 to 2018. Vet. Stanica 2021, 52, 149–158. [Google Scholar] [CrossRef]
- Holko, I.; Tančin, V.; Vršková, M.; Tvarožková, K. Prevalence and antimicrobial susceptibility of udder pathogens isolated from dairy cows in Slovakia. J. Dairy Res. 2019, 86, 436–439. [Google Scholar] [CrossRef]
- Hooper, D.C.; Jacoby, G.A. Mechanisms of drug resistance: Quinolone resistance. Ann. N. Y. Acad. Sci. 2015, 1354, 12–31. [Google Scholar] [CrossRef]
- Leghari, A.; Lakho, S.A.; Khand, F.M.; Lone, S.Q.; Aleem, M.T.; Iqra, B.; Chandio, M.A.; Shah, J.M.; Lin, H.-X.; Fan, H.-J. Molecular epidemiology, characterization of virulence factors and antibiotic resistance profile of Streptococcus agalactiae isolated from dairy farms in China and Pakistan. J. Integr. Agric. 2023, 22, 1514–1528. [Google Scholar] [CrossRef]
- Gao, J.; Barkema, H.W.; Zhang, L.; Liu, G.; Deng, Z.; Cai, L.; Shan, R.; Zhang, S.; Zou, J.; Kastelic, J.P. Incidence of clinical mastitis and distribution of pathogens on large Chinese dairy farms. J. Dairy Sci. 2017, 100, 4797–4806. [Google Scholar] [CrossRef]
- Ruegg, P.; Oliveira, L.; Jin, W.; Okwumabua, O. Phenotypic antimicrobial susceptibility and occurrence of selected resistance genes in gram-positive mastitis pathogens isolated from Wisconsin dairy cows. J. Dairy Sci. 2015, 98, 4521–4534. [Google Scholar] [CrossRef] [PubMed]
- Srinivasan, V.; Metcalf, B.J.; Knipe, K.M.; Ouattara, M.; McGee, L.; Shewmaker, P.L.; Glennen, A.; Nichols, M.; Harris, C.; Brimmage, M. vanG element insertions within a conserved chromosomal site conferring vancomycin resistance to Streptococcus agalactiae and Streptococcus anginosus. MBio 2014, 5, e01386-14. [Google Scholar] [CrossRef] [PubMed]
- Ikiz, S.; Başaran, B.; Bingöl, E.B.; Çetin, Ö.; Kaşikçi, G.; Özgür, N.Y.; Ucmak, M.; Yilmaz, Ö.; Gündüz, M.C.; Sabuncu, A. Presence and antibiotic susceptibility patterns of contagious mastitis agents (Staphylococcus aureus and Streptococcus agalactiae) isolated from milks of dairy cows with subclinical mastitis. Turk. J. Vet. Anim. Sci. 2013, 37, 569–574. [Google Scholar] [CrossRef]
- Naranjo-Lucena, A.; Slowey, R. Invited review: Antimicrobial resistance in bovine mastitis pathogens: A review of genetic determinants and prevalence of resistance in European countries. J. Dairy Sci. 2023, 106, 1–23. [Google Scholar] [CrossRef] [PubMed]
- Chohan, L.; Hollier, L.M.; Bishop, K.; Kilpatrick, C.C. Patterns of antibiotic resistance among group B streptococcus isolates: 2001–2004. Infect. Dis. Obstet. Gynecol. 2006, 2006, 57492. [Google Scholar] [CrossRef] [PubMed]
- Kuipers, A.; Koops, W.; Wemmenhove, H. Antibiotic use in dairy herds in the Netherlands from 2005 to 2012. J. Dairy Sci. 2016, 99, 1632–1648. [Google Scholar] [CrossRef] [PubMed]
- Almansour, A.M.; Alhadlaq, M.A.; Alzahrani, K.O.; Mukhtar, L.E.; Alharbi, A.L.; Alajel, S.M. The Silent Threat: Antimicrobial-Resistant Pathogens in Food-Producing Animals and Their Impact on Public Health. Microorganisms 2023, 11, 2127. [Google Scholar] [CrossRef] [PubMed]
- Botelho, A.C.; Ferreira, A.F.; Fracalanzza, S.E.; Teixeira, L.M.; Pinto, T.C. A perspective on the potential zoonotic role of Streptococcus agalactiae: Searching for a missing link in alternative transmission routes. Front. Microbiol. 2018, 9, 608. [Google Scholar] [CrossRef] [PubMed]
- Sørensen, U.B.S.; Klaas, I.C.; Boes, J.; Farre, M. The distribution of clones of Streptococcus agalactiae (group B streptococci) among herdspersons and dairy cows demonstrates lack of host specificity for some lineages. Vet. Microbiol. 2019, 235, 71–79. [Google Scholar] [CrossRef]
- Crestani, C.; Forde, T.L.; Lycett, S.J.; Holmes, M.A.; Fasth, C.; Persson-Waller, K.; Zadoks, R.N. The fall and rise of group B Streptococcus in dairy cattle: Reintroduction due to human-to-cattle host jumps? Microb. Genom. 2021, 7, 000648. [Google Scholar] [CrossRef]
Disclaimer/Publisher’s Note: The statements, opinions and data contained in all publications are solely those of the individual author(s) and contributor(s) and not of MDPI and/or the editor(s). MDPI and/or the editor(s) disclaim responsibility for any injury to people or property resulting from any ideas, methods, instructions or products referred to in the content. |
© 2024 by the authors. Licensee MDPI, Basel, Switzerland. This article is an open access article distributed under the terms and conditions of the Creative Commons Attribution (CC BY) license (https://creativecommons.org/licenses/by/4.0/).